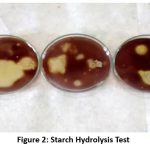

Manuscript accepted on : 08-05-2025
Published online on: 22-05-2025
Plagiarism Check: Yes
Reviewed by: Dr. Sudhanshu Kumar Bharti
Second Review by: Dr. Sharad Tripathi
Final Approval by: Dr. Eugene A. Silow
Aniruddha Ratnakar Apastambh1
and Mirza Mushtaq Vaseem Baig2*
1Department of Microbiology Indira Gandhi Sr. College, CIDCO, Nanded, Maharashtra, India.
2Department of Botany Yeshwant College, Nanded, Maharashtra, India.
Corresponding Author E-mail: mmvbaig@gmail.com
DOI : http://dx.doi.org/10.13005/bbra/3399
ABSTRACT: Thirty-four distinct bacillus strains were isolated and identified from various districts of the Marathwada region. These strains of Bacillus sp. were morphologically and biochemically characterised, such as shape, Gram's nature, and endospores forming ability, arginine hydrolysis, catalase test, hydrolysis of lipid, hydrolysis of casein, liquefaction of gelatin, starch hydrolysis, and urease test. The different plant growth-promoting properties of isolated Bacillus species investigated included IAA and GA₃ production, phosphate solubilisation, siderophore production, and HCN production. Isolates producing the highest amount of IAA, GA3, HCN, and phosphate solubilizers were selected for the plant growth promotion, including those isolates that show the highest antifungal activity. When a consortium of Bacillus species was used instead of individual strains, the roots and shoots showed greater length and dry weight. After 25 days of treatment, the consortium B4 produced the longest roots and shoots. After 25 days of treatment, consortia B3 showed the highest amount of dry weight of roots, while consortium B4 showed the highest amount of dry weight of shoots.
KEYWORDS: Consortium; GA3; HCN; IAA; Plant growth promotion
Download this article as:| Copy the following to cite this article: Apastambh A. R, Baig M. M. V. Enhanced Plant Growth and Biomass Accumulation via Bacillus spp. Consortia: A Functional Study for Wheat Growth. Biotech Res Asia 2025;22(2). |
| Copy the following to cite this URL: Apastambh A. R, Baig M. M. V. Enhanced Plant Growth and Biomass Accumulation via Bacillus spp. Consortia: A Functional Study for Wheat Growth. Biotech Res Asia 2025;22(2). Available from: https://bit.ly/4jdwSAM |
Introduction
The soil layer around plant roots, known as the rhizosphere, is critical to plant growth and development.1, 2 Rhizobacteria are bacterial communities that live in this region, and some of them, known as plant growth-promoting rhizobacteria (PGPR), have a favourable impact on plant growth. These PGPR promote plant growth directly or indirectly.3 These helpful rhizobacteria are classified into various genera, including Bacillus, Azotobacter, and Pseudomonas.
Bacillus is a genus of gram-positive bacteria commonly found in soil, with species such as Bacillus subtilis. 4 being diazotrophic. Extensive research has been conducted on the ability of Bacillus and Paenibacillus species to promote plant growth. 5, 6 It is well established that B. cereus, B. subtilis, and B. megaterium can serve as effective biocontrol agents against plant diseases. Additionally, antifungal peptides produced by species of Bacillus have the ability to regulate fungal growth.7
Paenibacillus and Bacillus are widely found in the rhizosphere. Very little information is available about this genus, but it is impossible that only a single species will dominate and outnumber other species in most soils.8 Many PGPR possess great potential as inoculants, and they can be used for agricultural purposes and environmental protection. These PGPR help to maintain the sustainability of agroecosystems. However, currently, PGPR are not effectively used in agriculture despite many positive reports in laboratory conditions. The use of a consortium of PGPR with different plant growth-boosting features can have a greater favourable impact on plant growth than using a single strain of PGPR. Inoculation of plants with mixed strains was found to be more effective than using a single strain.9 As a result, the purpose of this study was to determine the influence of a Bacillus sp. consortium on plant growth promotion.
Materials and Methods
Isoaltion and Characterization of Bacillus sp
Bacillus sp. from the rhizospheric zone were isolated as previously described.10 Colonies isolated were examined for their cell shape, gram reaction, and ability to form endospores.11 Bacillus species were identified as previously described. 12 Different biochemical tests were performed, such as arginine hydrolysis, catalase test, lipid hydrolysis, casein hydrolysis, gelatin liquefaction, starch hydrolysis, and urease test.
![]() |
Figure 1: Urease Test |
![]() |
Figure 2: Starch Hydrolysis Test |
![]() |
Figure 3: Arginine hydrolysis Test |
Determination of plant growth-promoting traits of Bacillus sp.
Isolated Bacillus species were investigated for their diverse plant growth-promoting characteristics, including as IAA production 13, gibberellic acid production 14, phosphate solubilisation, siderophore production 15, and HCN production.16
Antifungal Activity
The antifungal properties of Bacillus sp. was assessed as described.17 Fusarium oxysporum was cultured on plates containing PDA (potato dextrose agar) and was inoculated at the center of the plates. A bacterial culture of 24 hours old was streaked parallel 3-4 cm away from the disc on both sides. The incubation of these plates was done at 30oC for 96 hours.
Plant growth promotion experiment
The highest producers of IAA, GA, HCN, and Phosphate solubilizers were employed for the growth promotion experiment in selected plants, including those isolates that show the highest antifungal activity. A Plant growth promotion experiment was conducted as previously described.18 Wheat seeds were dipped in 0.02% sodium hypochlorite for two to three minutes and were then washed thrice with sterilized distilled water. Carboxymethylcellulose (CMC) 1% solution was used as an adhesive. The seeds were treated with a broth that contained 1 ×109 CFU/ml. Seeds were treated with each bacterial culture for 30 min and dried overnight. The four treated seeds were sown in soil containing pot and the length of the root, the shoot and the dry weight of the root and the shoot was noted on the eighth day, the fifteenth day and the twenty fifth day of treatment.
Plant growth promotion experiment using consortium of microorganisms
A plant growth promotion experiment using a consortium was conducted as previously described.19 The highest producers of IAA, GA, HCN, and Phosphate solubilizers were selected for the plant growth promotion experiment, including those isolates that show the highest antifungal activity. Wheat seeds were soaked for 2-3 minutes in 0.02% sodium hypochlorite, then washed three times with sterilised distilled water. The glue was made of 1% CMC (carboxymethylcellulose). Seeds were treated with broth containing 1 ×109 CFU/ml. The consortium had a 1:1 (v/v) ratio of each broth culture. Seeds were treated with each consortium culture for 30 minutes and then dried overnight. The four treated seeds were sown in soil containing a pot, and the length and dry weight of the root and shoot were measured on the eighth, fifteenth, and twenty-fifth days of treatment.
Results
A total of 34 Bacillus strains were isolated and identified from seven districts of Marathwada. These strains were characterized morphologically and biochemically. All isolates were gram-positive, rod-shaped, and motile, with the presence of endospores being a common characteristic. The isolates were tested for their ability to promote plant growth by producing siderophores, gibberellic acid, phosphate solubilization, IAA, and HCN. The strains producing the highest amounts of IAA, gibberellic acid, HCN, and those exhibiting the largest zones of phosphate solubilization and antifungal activity were selected for further investigation. Five Bacillus strains were chosen for the plant growth promotion experiment (Table 1). In this experiment, wheat seeds treated with Yb20 exhibited the longest root length after 15 days, while the highest shoot length of 16.55 cm was observed with Yb1 after 25 days of treatment (Table 3). After 25 days of treatment, the B4 consortium (IAA producer + GA producer + phosphate solubilizer + HCN producer + antifungal activity) had the best results in terms of root length, shoot length, and dry root and shoot weight for wheat seeds. The B4 consortium’s root and shoot lengths were 11.80 cm and 14.63 cm, respectively (Table 5). The highest dry weight of the root was seen with consortia B3, while the highest dry weight of the shoot was obtained by B4 after 25 days. This study found that the use of Bacillus sp. consortia was more effective in boosting plant growth, in terms of root and shoot length and root and shoot dry weight, than the use of individual Bacillus.
Table 1: Isolates of Bacillus Selected for Plant Growth Promotion Experiment.
| Sr.No | Isolate Code | Plant growth promoting trait |
| 1 | Yb8 | IAA production |
| 2 | Yb1 | GA production |
| 3 | Yb20 | Phosphate Solubilization |
| 4 | Yb34 | HCN production |
| 5 | Yb27 | Antifungal activity |
Table 2: Consortium of Bacillus used for the experiment
| Sr.No | Plant growth promoting trait | Consortium Code |
| 2 | IAA producer+ GA producer | B1 |
| 3 | IAA producer+ GA producer+ Phosphate Solubilizer | B2 |
| 4 | IAA producer+ GA producer+ Phosphate Solubilizer + HCN producer | B3 |
| 5 | IAA producer+ GA producer+ Phosphate Solubilizer + HCN producer+ Antifungal activity | B4 |
Table 3: Effect of Bacillus isolates on root length and shoot length of wheat seeds
| Sr. No | Isolate Code | Root Length (cm) | Shoot Length (cm) | ||||
| After 8 days | After 15 days | After 25 days | After 8 days | After 15days | After 25 days | ||
| 1 | Yb1 | 4.27 | 6.10 | 11.48 | 6.25 | 12.78 | 16.55 |
| 2 | Yb8 | 4.11 | 5.21 | 10.45 | 5.45 | 11.41 | 15.20 |
| 3 | Yb20 | 3.20 | 6.85 | 12.20 | 6.44 | 12.20 | 15.21 |
| 4 | Yb27 | 4.20 | 7.45 | 10.56 | 5.21 | 10.60 | 15.85 |
| 5 | Yb34 | 3.20 | 6.40 | 10.87 | 6.40 | 10.46 | 14.50 |
| 6 | Control | 3.10 | 6.10 | 9.80 | 5.20 | 9.89 | 12.10 |
| 7 | SE± | 0.09 | 0.27 | 0.39 | 0.15 | 0.27 | 0.37 |
| 8 | CD@ 5% | 0.29 | 0.81 | 1.10 | 0.45 | 0.82 | 1.11 |
![]() |
Figure 4: Effect of Bacillus isolates on wheat seeds |
Table 4: Effect of Bacillus isolates on dry root weight and dry shoot weight of wheat seeds.
| Sr. No | Isolate Code | dry root weight(mg)
|
dry shoot weight (mg) | ||||
| After 8 days | After 15 days | After 25 days | After 8 days | After 15days | After 25 days | ||
| 1 | Yb1 | 0.20 | 0.40 | 0.70 | 0.30 | 0.54 | 0.82 |
| 2 | Yb8 | 0.26 | 0.49 | 0.75 | 0.41 | 0.58 | 0.94 |
| 3 | Yb20 | 0.28 | 0.46 | 0.76 | 0.40 | 0.61 | 0.99 |
| 4 | Yb27 | 0.28 | 0.50 | 0.80 | 0.44 | 0.69 | 1.01 |
| 5 | Yb34 | 0.30 | 0.51 | 0.82 | 0.39 | 0.51 | 0.80 |
| 6 | Control | 0.20 | 0.45 | 0.70 | 0.30 | 0.45 | 0.75 |
| 7 | SE± | 0.007 | 0.017 | 0.030 | 0.014 | 0.020 | 0.032 |
| 8 | CD@ 5% | 0.021 | 0.55 | 0.092 | 0.042 | 0.062 | 0.095 |
Table 5: Effect of consortium of Bacillus isolates on root length and shoot length of wheat seeds
| Sr. No | Isolate Code | Root Length (cm) | Shoot Length (cm) | ||||
| After 8 days | After 15 days | After 25 days | After 8 days | After 15days | After 25 days | ||
| 1 | B1 | 4.01 | 7.12 | 11.44 | 6.01 | 11.98 | 15.21 |
| 2 | B2 | 5.01 | 8.25 | 12.24 | 5.08 | 11.24 | 14.10 |
| 3 | B3 | 5.54 | 7.54 | 12.20 | 5.98 | 11.66 | 15.20 |
| 4 | B4 | 4.45 | 7.14 | 12.30 | 6.10 | 12.64 | 16.25 |
| 6 | Control | 4.01 | 7.44 | 11.06 | 5.54 | 10.66 | 12.85 |
| 7 | SE± | 0.10 | 0.18 | 0.40 | 0.11 | 0.26 | 0.41 |
| 8 | CD@ 5% | 0.30 | 0.57 | 1.22 | 0.35 | 0.80 | 1.24 |
![]() |
Figure 5: Effect of consortium of Bacillus sp on wheat seeds |
Table 6: Effect of consortium of Bacillus isolates on dry root weight and dry shoot weight of wheat seeds
| Sr. No | Isolate Code | Dry Root Weight(mg) | Dry Shoot Weight(mg) | ||||
| After 8 days | After 15 days | After 25 days | After 8 days | After 15days | After 25 days | ||
| 1 | B1 | 0.21 | 0.45 | 0.71 | 0.35 | 0.56 | 0.85 |
| 2 | B2 | 0.26 | 0.51 | 0.80 | 0.45 | 0.60 | 1.11 |
| 3 | B3 | 0.30 | 0.56 | 0.86 | 0.40 | 0.69 | 1.02 |
| 4 | B4 | 0.28 | 0.52 | 0.89 | 0.44 | 0.79 | 1.35 |
| 6 | Control | 0.21 | 0.44 | 0.65 | 0.35 | 0.51 | 0.81 |
| 7 | SE± | 0.011 | 0.018 | 0.029 | 0.015 | 0.024 | 0.037 |
| 8 | CD@ 5% | 0.035 | 0.055 | 0.087 | 0.045 | 0.074 | 0.11 |
Discussion
PGPR exert beneficial effects on plants by different mechanisms such as the production of phytohormones, phosphate solubilization, nitrogen fixation, and biocontrol.20 Bacillus is a common bacterium genus in the rhizosphere, and the plant growth-promoting properties of numerous of its strains have been well researched, revealing the mechanisms involved.21 Field investigations with microbial consortia of Pseudomonas, Azospirillum, and Bacillus on Withania somnifera showed significant increases in plant height and root length compared to individual strains.22 This suggests that combining soil microbial diversity to form consortia of two or more plant growth-promoting rhizobacteria (PGPR) can improve plant development.
The findings of this study highlight the significant potential of Bacillus spp. consortia for increasing wheat growth by improving nutrient uptake, stress tolerance, and overall plant health. The observed increases in root and shoot biomass, length, and yield metrics demonstrate the efficacy of these beneficial bacteria in promoting sustainable agriculture methods.23 This technique, which takes advantage of the plant growth-promoting capabilities of Bacillus spp., offers a possible alternative to artificial fertilisers, contributing to environmentally friendly and resilient wheat agriculture. Additional study is required to optimise application methods and assess the long-term impacts on soil health and crop output.
Conclusion
For promoting plant growth, a consortium of microorganisms may be more effective than a single strain. Numerous Bacillus sp. isolates have several characteristics that promote plant development. These isolates can be applied to agriculture with success. Utilizing these bacteria for sustainable agriculture can be aided by research on their variety.
Acknowledgement
The author would like to thank the Department of biotechnology, Yeshwant Mahavidyalaya, Nanded, Maharashtra for carrying out research work.
Funding Sources
The author(s) received no financial support for the research, authorship, and/or publication of this article.
Conflict of Interest
The authors do not have any conflict of interest.
Data Availability Statement
This statement does not apply to this article.
Ethics Statement
This research did not involve human participants, animal subjects, or any material that requires ethical approval.
Informed Consent Statement
This study did not involve human participants, and therefore, informed consent was not required.
Clinical Trial Registration
This research does not involve any clinical trials.
Permission to reproduce material from other sources
Not Applicable
Author Contributions
Aniruddha Ratnakar Apastambh: Methodology, Data Collection, Writing – Original Draft, Review
Mirza Mushtaq Vaseem Baig: Analysis, Editing, Supervision, Conceptualization.
References
- Saharan B.S., and Nehra V. Plant growth promoting rhizobacteria: A critical review. Life Sci and Med Res. 2011; 21:1-30.
- Hrynkiewicz K and Baum C. The potential of rhizosphere microorganisms to promote the plant growth in disturbed soils. In: Malik A, Grohmann E (eds) Env prot str for sust dev. Springer, Berlin, 2012; pp 35–64.
CrossRef - Luana Alves, Carlos H. B., Edvan T. F., Luziane R. S. and Everlon C R. Plant Growth-Promoting Rhizobacteria for Sustainable Agricultural Production. Microorg. 2023; 11:1-16 https://doi.org/10.3390/microorganisms11041088
CrossRef - Timmusk S, Nicander B, Granhall U, Tillberg E. Cytokinin production by Paenibacillus polymyxa. Soil biol and biochem 1999; 31:1847–1852. 10.1016/S0038-0717(99)00113-3
CrossRef - Choudhary D.K., Johri B.N. Interactions of Bacillus spp. and plants – with special reference to induced systemic resistance (ISR). Microbiol res. 2008; 164:493–513. 10.1016/j.micres.2008.08.007
CrossRef - Kloepper J.W., Ryu C.M. Zhang S. Induced systemic resistance and promotion of plant growth by Bacillus spp. Phytopathol. 2004; 94:1259–1266. 10.1094/PHYTO.2004.94.11.1259
CrossRef - Kildea S. S. Ransbotyn, M.R. Khan, B. Fagan, G. Leonard, E. Mullins . B. megaterium shows potential for the biocontrol of septoria tritici blotch of wheat Biol Contr. 2008; 47:37–45
CrossRef - Liu Z.L., Sinclair J.B. Genetic diversity of Rhizoctonia solani group 2. Phytopathol .1992;82:778-787
CrossRef - Adesemoye A.O., Obini M., Ugoji E.O. Comparison of plant growth-promotion with Pseudomonas aeruginosa and Bacillus subtilis in three vegetables. Braz J. of Microbiol. 2008; 39:423–426 10.1590/S1517-83822008000300003
CrossRef - Travers R.S., Martin P.A.W., Reichelderfer C.F. Selective isolation of soil Bacillus spp. Appl and Env microbial. 1987; 53:1263-1266
CrossRef - Bartholomew, J. W. and Mittewar T. A. Simplified bacterial strain. Strain Tech. 1950; 25: 153
CrossRef - Anonymous. Man of Microbiol Meth. Mc.Graw Hill Book Co. Society of American Bacteriologists, New York. 1957; 315
- Gordon S.A., Weber R.P. Colorimetric estimation of indole acetic acid. Pl Physiol. 1951; 26(1):192–195
CrossRef - Paleg L.G. Physiological effects of gibberellins. Ann rev of pl physiol.1965; 6: 291-322.
CrossRef - Schwyn B. and Neilands J.B. Universal chemical assay for the detection and determination of siderophores. Ann of biochem.1987;160:47-56.
CrossRef - Wei G., Kloepper J.W. and Sadik T. Induction of systemic resistance of cucumber to Colletotrichum orbiculate by select strains of plant growth promoting rhizobacteria. Phytopathol 1991;81:1508-1512.
CrossRef - Ganesan P. Gnanamanickam S.S. Biological control of Sclerotium rolfsii in pea nut by inoculation with P. fluoresencs. Soil boil and biochem.1987;35–38.
CrossRef - Weller, D.M. and Cook, R.J. Suppression of take-all of wheat by seed treatments with fluorescent Pseudomonads. Phytopathol. 1983; 73:463-69.
CrossRef - Sindhu S.S., Sunita Suneja, Goel A.K., Parmar N., Dadarwal K.R. Plant growth promoting effects of Pseudomonas sp. on coinoculation with Mesorhizobium sp. Cicer strain under sterile and “wilt sick” soil conditions. Appl soil ecol. 2002; 19:57–64. https://doi.org/10.1016/S0929-1393(01)00176-7
CrossRef - Asma Hasan , Baby Tabassum, Mohammad Hashim, Nagma Khan Role of Plant Growth Promoting Rhizobacteria (PGPR) as a Plant Growth Enhancer for Sustainable Agriculture: A Review. Preprints.2023 doi:10.20944/preprints202310.1504.v1
CrossRef - Gutierrez-Manero F.J., Ramos B., Probanza A., Mehouachi J, Talon M. The plant growth promoting rhizobacteria Bacillus pumilus and Bacillus licheniformis produce high amounts of physiologically active gibberelins. Physiol Planta 2001; 111:206–211. https://doi.org/10.1034/j.1399-3054.2001.1110211.x
CrossRef - Rajasekar S, Elango R. Effect of microbial consortium on plant growth and improvement of alkaloid content in Withania somnifera (Ashwagandha). Curr bot. 2011; 2:27–30.
- Kothari M. N. and Baig M. M. V. Production and Characterization of Extracellular Polygalacturonase by Erwinia carotovora MTCC 1428. Int. J. of Adv. Biotech. and Res. 2013; 4(1): 118-122.

This work is licensed under a Creative Commons Attribution 4.0 International License.